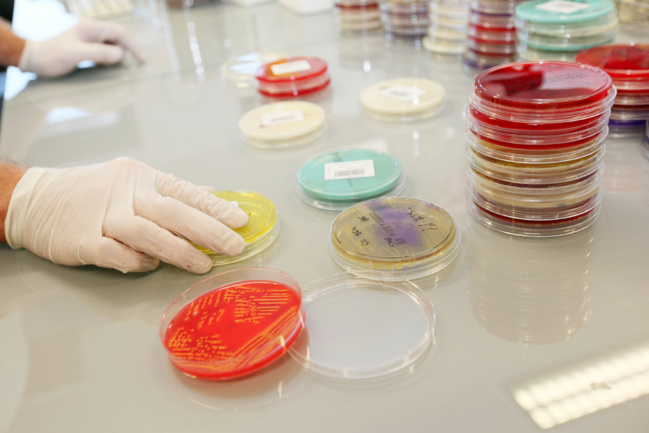

À retenir
- Le microbiote intestinal est modifié chez les sujets ayant une forme avancée de pathologie cardiométabolique (obésité, diabète de type 2, maladie coronarienne, insuffisance cardiaque).
- Les médicaments ont un impact au moins aussi important que les maladies elles-mêmes sur la composition du microbiote.
- Bien que l’impact des traitements sur le microbiote semble modeste (environ 2% du microbiote serait modifié), ce déséquilibre est pourtant associé à des modifications biologiques ou cliniques significatives.
Méthodologie
Metacardis (Metagenomic in Cardiometabolic Disease) est un programme de recherche qui explore les liens entre microbiote intestinal et maladies cardiométaboliques. Il a été lancé en 2012 et il est mené par un consortium international de 14 organisations scientifiques issues de 6 pays européens. Ce programme est coordonné par l’Inserm. Les chercheurs ont développé des algorithmes pour distinguer l’influence de facteurs tels que l’alimentation, l’activité physique, le tabac, les médicaments, etc sur le microbiote intestinal d’individus classés en sous-populations en fonction de leur état de santé, de leurs traitements et de leur alimentation.
Les chercheurs ont analysé les signatures microbiennes imputables aux différentes maladies de celles imputables aux traitements à partir d’ADN bactériens et de métabolites issus d’échantillons de selles.
Principaux résultats
Les données de l’étude portent sur une cohorte de 2.173 sujets dont le mode de vie a été soigneusement documenté. Les participants prenaient en moyenne trois médicaments quotidiennement, principalement des hypolipémiants (dont statines), antidiabétiques, antihypertenseurs, antithrombotiques, antiarythmiques, inhibiteurs de la pompe à protons ou antibiotiques.
Les résultats montrent un impact au moins aussi important des médicaments et des maladies sur la composition du microbiote intestinal. Les chercheurs ont montré que l’impact des médicaments différait selon que ces derniers étaient pris en monothérapie ou en association. Les statines, la metformine, les antibiotiques et les inhibiteurs de la pompe à protons sont parmi ceux qui modifiaient le plus l’équilibre du microbiote intestinal. La variation de la diversité du microbiote, estimée à seulement 2% suffirait cependant à induire des modifications biologiques ou cliniques significatives